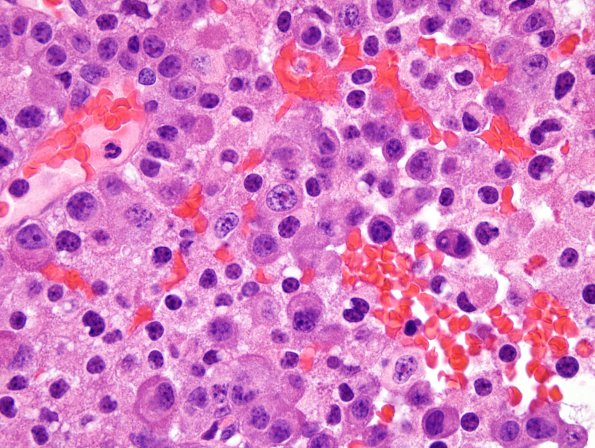
9B3 PA CR (Case 9) H&E 1.jpg

Table of Contents
Washington University Experience | NEOPLASM (SELLAR) | Pituitary Adenoma - Pituitary Neuroendocrine Neoplasm | Corticotroph | 9B3 PA CR (Case 9) H&E 1.jpg
Occasional groups of cells and single cells show large atypical nuclei. Additionally, many tumor cells exhibit a perinuclear cytoplasmic ring of pale eosinophilic hyalinized material, consistent with Crooke's hyaline change. Mitotic figures are rare.